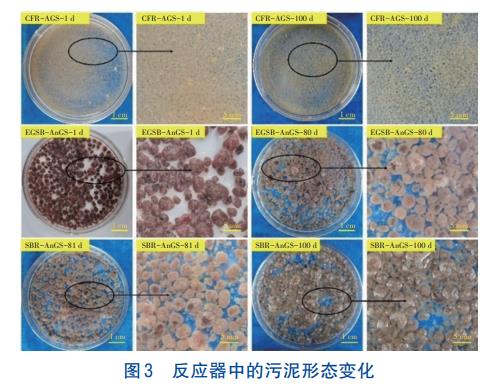
8.jpg

赣南离子型稀土矿山在开采过程中会产生大量含氮尾水,该尾水呈酸性无机高氨氮废水特征,已成为区域重要污染源。由于难以准确收集,目前的做法是在矿区流域的下游合适地点设置尾水处理站以阻控污染物向干流断面的输送。赣南已建成了数座离子型稀土矿山尾水治理工程,采用的技术主要是生化法,但普遍存在缺乏有机碳源导致运行成本居高不下这一问题。
好氧颗粒污泥(AGS)是微生物自凝聚形成的颗粒聚合体,具有生物密度高、结构致密、耐毒性强、沉降速度快等优点,被认为是极具发展前景的新一代废水生化处理技术。与传统生化处理工艺(例如A2/O、氧化沟、生物滤池等)相比,AGS技术能实现单级脱氮,承受更高的氮负荷,而运行成本相对更低。虽然AGS的处理对象主要为有机废水,但研究表明无机高氨氮废水中AGS因增殖缓慢反而更容易维持相对稳定,说明AGS具有处理离子型稀土矿山尾水的潜力。不足的是,无机废水中AGS亦会因缺少有机碳源而导致反硝化细菌脱氮能力不高。另外,绝大多数AGS系统采用的是间歇式运行模式,连续流AGS反应器仍比较少见。根据选择性排泥机制,已报道的连续流AGS反应器包括:筛网筛分型、三相分离器型、离心分离型、膜分离型、专用沉淀池型等。然而,这些构型的连续流AGS反应器能否实现AGS长期稳定性维持仍需检验。
厌氧氨氧化颗粒污泥(AnGS)是厌氧微生物(主要是厌氧氨氧化菌)自凝聚形成的颗粒状生物聚合体,具有沉降快、脱氮效率高、运行能耗低等优点。与传统硝化反硝化工艺相比,厌氧氨氧化工艺可节约60%以上的曝气量,减少80%~90%的污泥产量,无需有机碳源,被认为是一种可持续的污水脱氮工艺。AnGS反应器可分为连续流及间歇式两种。以膨胀颗粒污泥床(EGSB)为代表的连续流工艺具有运行灵活、易与其他连续流工艺串联等优点,但反应器结构复杂;以序批式反应器(SBR)为代表的间歇式反应器具有传质推动力大、结构简单等优点,但存在水头损失大、不易与连续流工艺串联等不足。可见,两类反应器各有优缺点,究竟何种反应器形式更能发挥AnGS的脱氮优势,目前缺少系统研究。
厌氧氨氧化反应需要维持稳定的亚硝态氮积累,这也是该技术应用推广的主要制约因素。研究表明,通过限氧曝气能够实现连续流反应器(CFR)中AGS稳定性维持及亚硝态氮稳定积累,这一优势具备成为AnGS前置半量短程硝化的潜力。为此,笔者分别考察了CFR中AGS半量短程硝化耦合EGSB及SBR中AnGS的脱氮效果,以期为离子型稀土矿山尾水的治理提供技术支撑。
1、材料与方法
1.1 试验装置
①前置CFR
CFR由主反应器(内径为20cm,有效水深为1.8m,高径比为9,有效容积约为56.5L)、斜管(内径为4cm,有效长度为30cm,水平夹角为60°)、挡板沉淀池(内径为20cm,有效水深为50cm,有效容积约为11.5L)等组成(见图1),总有效容积约为70.5L。

通过电磁式空气泵(曝气量为90L/min)将压缩空气从主反应器底部的曝气头通入。反应器连续进、出水,通过蠕动泵将模拟废水从进水池抽入主反应器内(流量为6.65L/h)。压缩空气带动混合液在主反应器内上下运动,其中一部分混合液经斜管分流至挡板沉淀池内,上清液从出水口排出,AGS在重力作用下沉淀,通过回流污泥管回流至主反应器(管径为3cm,回流口距底部20cm)。挡板沉淀池内部设置有可调节挡板,运行过程中深入液面以下27cm。通过变频电加热棒为反应器提供保温(水温维持在27~30℃)。该CFR本质上亦属于通过三相分离器实现泥水分离,但将EGSB中一体式三相分离器分成斜管+挡板沉淀池来实现污泥选择性筛分,可通过调节挡板深度改变水力选择压。
②EGSB和SBR
EGSB主体部分内径为7cm,高径比为16,有效容积为4.2L,外部采用遮光保护膜包裹,详见图2(a)。通过蠕动泵将CFR的出水从中间水池抽入EGSB。1~60d控制进水流速为0.26L/h,水力停留时间(HRT)为16h;61~80d控制进水流速为0.37L/h,HRT为11.4h。通过变频电加热棒为反应器提供保温,水温维持在35℃左右。

SBR高度为40cm,内径为19.2cm,有效容积为8L,换水率为50%,具体见图2(b)。将CFR出水从中间水池抽入SBR。每天运行4个周期(6h),包括进水(5min)、搅拌(350min)、沉淀(3min)及出水(2min)。通过机械搅拌器(转速为150~230r/min)实现泥水混合,试验过程中水温维持在28~32℃。
1.2 接种污泥
①AGS
前置CFR中接种的AGS呈浅黄色,沉降30min污泥体积与污泥体积之比(SV30/SV5)为0.97,污泥体积指数(SVI)约为58.52mL/g,颗粒化率为93.90%,平均粒径为0.64mm,MLVSS/MLSS为0.89,比耗氧速率(SOUR)为56.60mgO2/(gMLVSS·h),胞外聚合物(EPS)含量为28.12mg/gMLVSS,其蛋白质与多糖含量之比(PN/PS)为1.56。AGS接种至CFR中的起始MLSS约为4000mg/L。
②AnGS
EGSB中接种的AnGS为红色颗粒状,SV30/SV3为1.00,SVI为55.52mL/g,平均粒径约为2.23mm,颗粒化率为92.98%,MLVSS/MLSS约为0.54。第81天时将EGSB中的AnGS接种至SBR。AnGS接种至EGSB中的起始MLSS约为6000mg/L。
1.3 模拟废水
前置CFR进水为模拟离子型稀土矿山尾水,由氯化铵提供氨氮、碳酸氢钠提供碱度,调节pH在7.0~7.5之间,同时根据Zeng等推荐的配方浓度添加钙、铁、镁、磷及其他微量元素。反应器各阶段具体的进水水质见表1。

CFR出水由中间水池(容积为100L,2个交替使用)收集,进入下一级反应器前投加叶酸、K2HPO4、MgSO4·7H2O及CaCl2·2H2O,浓度分别控制在1μmol/L、2mg/L、5mg/L及3mg/L。第1~80天CFR出水进入EGSB(日处理水量为6.24和8.88L),第81~100天CFR出水进入SBR(日处理水量为16L),具体流量及HRT等参数见表2。CFR运行流量远大于二级反应器,除先后进入EGSB及SBR外,中间水池中多余一级出水排入实验室内其他厌氧氨氧化反应器。

1.4 分析测试方法
氨氮、亚硝态氮、硝态氮、pH、DO、SV、SVI、MLSS、MLVSS等均采用国家标准方法测定,总无机氮(TIN)为氨氮、亚硝态氮和硝态氮三者之和。利用数码相机记录污泥形态变化。SOUR采用Ochoa等推荐的方法测定。EPS采用热提取法进行提取,其中的PN采用改进Lowry法测定,PS采用硫酸苯酚法测定。污泥平均粒径及颗粒化率采用龙焙等推荐的方法测定。
亚硝酸盐积累率(NAR)及同步硝化反硝化率(SND)的计算公式如下:


式中:CNO2-N为反应器出水NO2--N浓度,mg/L;CNO3--N为反应器出水NO3--N浓度,mg/L;δNH4+-N为反应器内NH4+-N的去除量,mg/L。
游离氨(FA)及游离亚硝酸(FNA)浓度的计算公式如下:

式中:C'NH4+-N、C'NO2--N分别为反应器内氨氮、亚硝态氮浓度,;T为水温,℃。
2、结果与讨论
2.1 污泥颗粒形态及理化指标
启动时,CFR中绝大多数污泥为粒径较小的AGS,夹杂着少量大颗粒,形状不规则(见图3)。运行过程中AGS颜色及形状并无明显变化,但大颗粒数量明显减少。通常认为连续流中较低的传质推动力是导致AGS粒径偏小的主要原因。100d时污泥浓度在左右,的和SV30/SV5分别在65mL/g和0.9左右,平均粒径和颗粒化率分别在0.57mm和95%左右,EPS含量和PN/PS分别在30mg/gMLSS和1左右。可见,污泥沉降性能略有下降,MLSS略有减小,原因之一是在连续流的低传质推动力下部分颗粒污泥解体后随出水排出。

接种AnGS颗粒饱满,外表光滑。EGSB中的AnGS形状变化不大,但红色逐渐变浅。AnGS中高含量的血红素使厌氧氨氧化污泥呈鲜红色,颜色变浅意味着AnGS酶活性降低。SBR中的AnGS形状亦无明显变化,但至第100天时颜色比EGSB中的更深。第80天时EGSB的污泥浓度约为5200mg/L,AnGS的SVI和SV30/SV5分别在和左右,平均粒径和颗粒化率分别在2.2mm和97%左右。第100天时SBR的污泥浓度约为5400mg/L,AnGS的SVI和SV30/SV5分别在和左右,平均粒径和颗粒化率分别在2.3mm和98%左右。可见,AnGS的沉降性能变化不大,但EGSB中的MLSS明显减小,接种至SBR后MLSS略有增大。
2.2 前置AGS半量短程硝化
前置CFR的出水水质如图4所示。

CFR出水氨氮浓度在前25d波动较大,在31.59~155.51mg/L之间;在第26~80天,通过减少曝气量和碱度投加量控制氨氮氧化,出水氨氮基本维持在70~90mg/L之间;在第81天降低进水氨氮及碱度后,出水氨氮维持在40~45mg/L之间。出水亚硝态氮浓度在前25d先降低后逐渐升高至128mg/L以上;在第26~80天,出水亚硝态氮逐渐降低至86.76~120.98mg/L;在第81~100天,出水亚硝态氮维持在50~57mg/L之间。出水硝态氮浓度在前25d波动较大,处于2.38~46.22mg/L之间;在第26~80天,出水硝态氮基本维持在9~31mg/L之间;在第81~100天,出水硝态氮维持在7~10mg/L之间。出水TIN浓度在前80d基本维持在189~289mg/L之间,在第81~100天维持在100~110mg/L之间。
氨氮去除率在前25d波动较大,在61.12%~90.10%之间,此后逐渐稳定在70%~80%之间。TIN去除率在前25d处于31%~50%之间,此后逐渐稳定在25%~35%之间。此结果表明AGS具有内源脱氮能力,这是导致MLSS降低的另一重要原因。NAR基本保持在80.27%~98.59%之间。可见,通过降低进水氨氮浓度、减少曝气量及碱度补偿,可以限制氨氮的氧化程度,自第32天开始出水亚硝态氮与氨氮比值基本控制在1.0~1.3之间,实现了稳定的半量短程硝化。
2.3 EGSB中AnGS的脱氮性能
EGSB出水氨氮浓度在前7d快速升至119.76mg/L,第8~60天多数在30mg/L以下,在第61~80天升至30~45mg/L左右(见图5)。出水亚硝态氮浓度前25d整体呈增大趋势(48.78~176.52mg/L),此后基本保持在52~93mg/L。出水硝态氮浓度在前25d逐渐增至53.27mg/L左右,第26天迅速降至17.06mg/L,至第45天时又逐渐升至55.61mg/L左右,此后基本维持在61~88mg/L。出水TIN浓度前25d在194.02mg/L左右,第26~30天迅速降低,此后缓慢升高,67d后保持在180~190mg/L左右。

EGSB对氨氮的去除率波动较大,大部分在50%~80%之间。EGSB对TIN的去除率除第29~34天在60%左右外,在第1~25天和第35~80天TIN去除率均呈下降趋势,65d后TIN去除率基本不超过10%。TIN去除效果的恶化与观察到的AnGS红色变浅及MLSS的减小相吻合。
2.4 SBR中AnGS的脱氮性能
SBR出水氨氮浓度逐渐降低并趋于稳定,第90天后基本保持在9~12mg/L之间(见图6(a))。出水亚硝态氮浓度变化趋势与出水氨氮类似,第87天后维持在13~18mg/L之间。出水硝态氮浓度变化不大,基本维持在7~18mg/L之间。出水TIN浓度在第81~91天内整体呈降低趋势(100.88mg/L→36.16mg/L),此后基本维持在30~40mg/L之间。TIN及氨氮去除率在第81~83天不稳定,第84~92天两者均呈增大趋势,此后氨氮去除率维持在72%~78%之间、TIN去除率基本维持在60%~70%之间。

如图6(b)所示,在典型周期内,氨氮和亚硝态氮浓度在前4h内逐渐降低,此后趋于稳定;硝态氮浓度在前3h内整体呈升高趋势,此后逐渐降低;TIN浓度整体呈降低趋势;pH不断降低,除了厌氧氨氧化反应会消耗碱度外,推测是前置CFR出水会携带一部分氨氧化细菌(AOB)及DO(实测值在0.1~1.2mg/L之间)进入二级SBR,AOB氧化部分氨氮亦会导致pH降低。氨氮及亚硝态氮浓度的同步降低印证了厌氧氨氧化反应的发生。同时,前置CFR出水会携带一部分反硝化细菌进入二级SBR,使反应器具备一定的内源反硝化能力,因而3h后硝态氮浓度逐渐降低。
2.5 SND、NAR、FA和FNA
在前置CFR中,NAR大部分保持在80%~90%之间;SND在前25d整体呈降低趋势,之后大部分时间保持在40%~50%之间,这与前置CFR的TIN去除率在30%~40%左右相吻合。研究表明,FA对AOB起始抑制浓度范围在10~150mg/L,对亚硝酸盐氧化菌(NOB)的起始抑制浓度范围在0.1~10.0mg/L;FNA对AOB和NOB也具有抑制作用,抑制浓度范围分别为0.22~2.80和0.01~0.22mg/L。各反应器内游离氨与游离亚硝酸浓度的变化如图7所示。在CFR中,FA浓度在前25d基本处于20mg/L以上,可见其已经对AOB产生抑制,这也与系统脱氮性能不佳相符合,且不利于短程硝化的实现;降低进水氨氮浓度后,第26~100天FA浓度逐渐降至5mg/L以下,实现了对AOB和NOB的选择性抑制。FNA浓度在前25d基本维持在0.01mg/L以下,未对NOB产生明显抑制,此后其浓度波动较大,在0.01~0.11mg/L之间,说明FNA在中后期也对NOB产生了抑制。可见,FA对NOB的选择性抑制是实现稳定半量短程硝化的主要原因。

EGSB中FA和FNA浓度的变化趋势与前置CFR类似,FA浓度在前25d处于5~55mg/L之间,此后基本保持在5mg/L以下;FNA浓度在前25d基本保持在0.01mg/L以下,此后保持在0.01~0.08mg/L之间。SBR中的FA浓度大部分在1mg/L以下,FNA在0.002~0.024mg/L之间。袁砚等研究发现FA对厌氧氨氧化菌(AnAOB)的起始抑制浓度范围为2~35mg/L,当FA>35mg/L时,菌将不适应该环境;等研究发现当FNA<0.0066mg/L时,比厌氧氨氧化速率不受影响,而将FNA浓度提高到0.011mg/L时,比厌氧氨氧化速率将降低50%。可见,EGSB中第61~80天FNA浓度的增大可能是阶段Ⅲ脱氮性能下降及MLSS减小的主要原因。相比之下,SBR中FA及FNA几乎未对AnAOB菌起到抑制作用,因而实现了更高的TIN去除率,而且MLSS略有增大。
2.6 脱氮效果对比
随着进水氨氮浓度的降低及水力负荷的增大,CFR-EGSB对TIN的去除率除在第22~34天呈升高趋势外,在第1~21天及第35~80天内均呈降低趋势,使得EGSB对TIN去除的贡献率逐渐降至10%以内(见图8);在第81~100天,CFR-SBR对TIN的去除率整体呈增大趋势(32.75%~80.36%),使得SBR对TIN去除的贡献率逐渐增至60.00%左右。

CFR-EGSB为全连续流工艺,两级反应器之间容易串联,反应器容积利用率高。相比之下,CFRSBR工艺之间串联更复杂,容积利用率更低。然而,实际运行中发现CFR-EGSB对水质变化更加敏感,脱氮效率明显低于CFR-SBR。这是因为EGSB的运行参数调控更加复杂,需要兼顾氮负荷、进水流量、回流比等以实现最佳脱氮,本试验中为避免水力负荷过高导致“跑泥”而未设置出水回流可能是导致AnGS活性被抑制的另一原因。CFR-SBR中SBR的批次进水有利于水质的均化,反应过程中的搅拌使得泥水混合更均匀,因而传质推动力及传质效率更高、脱氮效果更好。对照《离子型稀土矿山开采水污染物排放标准》(DB361016-2018),CFR-SBR的出水氨氮已基本满足该标准要求(≤15mg/L),但出水总氮尚不满足30mg/L的限值要求,后续研究需优化中间水池设计,避免前置CFR出水污泥及DO对二级SBR的影响,其次优化反应器设计,使两级系统水质水量全匹配运行以实现高效自养脱氮。
3、结论
①通过限氧曝气和进水氨氮及碱度调控,于35d后在CFR中实现半量短程硝化,出水氨氮与亚硝态氮比值在1∶1.01~1∶1.36之间,反应器内以小粒径的AGS为主(平均粒径约为0.57mm)。
②CFR-EGSB串联工艺的脱氮效果不稳定,在第26~60天对TIN的去除率最高可达78.83%,但随后逐渐降至24.84%;EGSB中第61~80天FNA浓度的增大可能是阶段Ⅲ脱氮性能下降的主要原因;EGSB中AnGS颗粒饱满,但红色逐渐变浅,对TIN去除的贡献率在3.32%~71.65%之间。
③CFR-SBR串联工艺对TIN的去除率明显更高,逐渐增至80.36%;SBR中AnGS颗粒仍然饱满,但是颜色逐渐变深,对TIN去除的贡献率在3.32%~60.00%之间。(来源:赣州市政务服务中心,江西理工大学土木与测绘工程学院)



